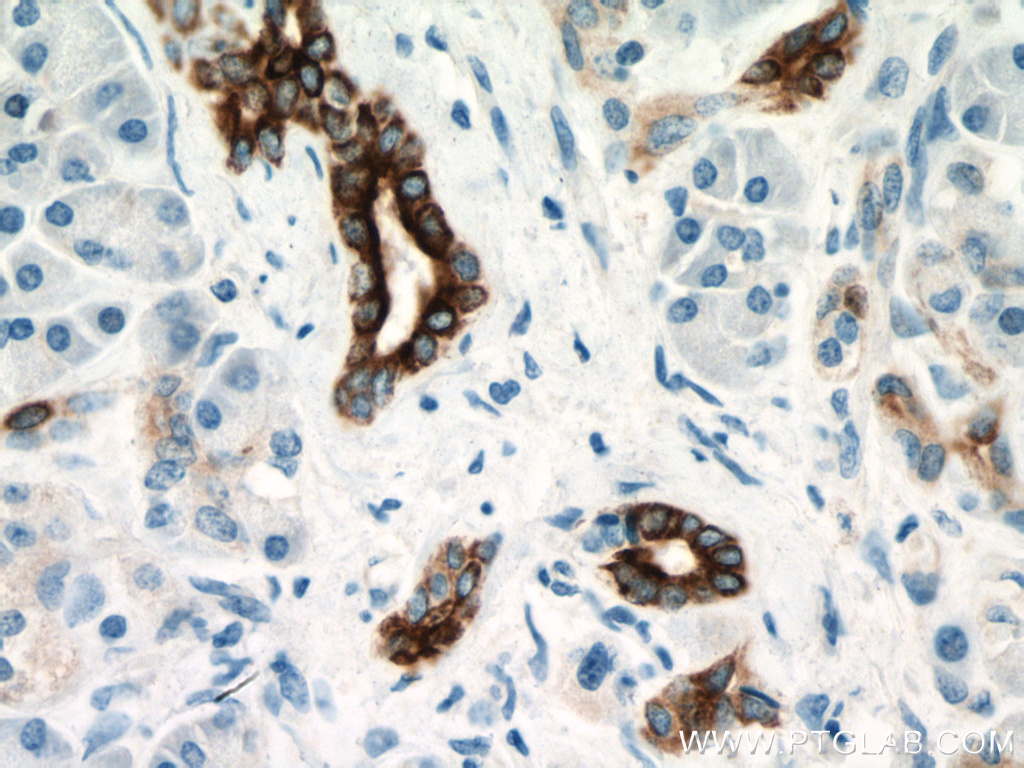

验证数据展示
经过测试的应用
| Positive WB detected in | A549 cells, A431 cells, T-47D cells, PC-3 cells, HeLa cells, HepG2 cells, BxPC-3 cells |
| Positive IHC detected in | human lung cancer tissue, human ovary tumor tissue, human kidney tissue, human pancreas tissue, human breast cancer tissue Note: suggested antigen retrieval with TE buffer pH 9.0; (*) Alternatively, antigen retrieval may be performed with citrate buffer pH 6.0 |
| Positive IF-P detected in | human prostate cancer tissue |
推荐稀释比
| 应用 | 推荐稀释比 |
|---|---|
| Western Blot (WB) | WB : 1:10000-1:40000 |
| Immunohistochemistry (IHC) | IHC : 1:500-1:2000 |
| Immunofluorescence (IF)-P | IF-P : 1:200-1:800 |
| It is recommended that this reagent should be titrated in each testing system to obtain optimal results. | |
| Sample-dependent, Check data in validation data gallery. | |
产品信息
66483-1-Ig targets Cytokeratin 7 in WB, IHC, IF-P, ELISA applications and shows reactivity with Human samples.
| 经测试应用 | WB, IHC, IF-P, ELISA Application Description |
| 文献引用应用 | WB, IHC, IF |
| 经测试反应性 | Human |
| 文献引用反应性 | human, mouse |
| 免疫原 |
CatNo: Ag7895 Product name: Recombinant human CK7 protein Source: e coli.-derived, PGEX-4T Tag: GST Domain: 1-351 aa of BC002700 Sequence: MSIHFSSPVFTSRSAAFSGRGAQVRLSSARPGGLGSSSLYGLGASRPRVAVRSAYGGPVGAGIREVTINQSLLAPLRLDADPSLQRVRQEESEQIKTLNNKFASFIDKVRFLEQQNKLLETKWTLLQEQKSAKSSRLPDIFEAQIAGLRGQLEALQVDGGRLEAELRSMQDVVEDFKNKYEDEINRRTAAENEFVVLKKDVDAAYMSKVELEAKVDALNDEINFLRTLNETELTELQSQISDTSVVLSMDNSRSLDLDGIIAEVKAQYEEMAKCSRAEAEAWYQTKFETLQAQAGKHGDDLRNTRNEISEMNRAIQRLQAEIDNIKNQRAKLEAAIAEAEERGELALKDAR 种属同源性预测 |
| 宿主/亚型 | Mouse / IgG2a |
| 抗体类别 | Monoclonal |
| 产品类型 | Antibody |
| 全称 | keratin 7 |
| 别名 | Cell and organelle markers, CK 7, CK7, Cytokeratin 7, Cytoskeleton Marker, K2C7, K7, keratin 7, KRT7, Sarcolectin, SCL, Type II keratin Kb7 |
| 计算分子量 | 469 aa, 51 kDa |
| 观测分子量 | 51 kDa |
| GenBank蛋白编号 | BC002700 |
| 基因名称 | Cytokeratin 7 |
| Gene ID (NCBI) | 3855 |
| RRID | AB_2881849 |
| 偶联类型 | Unconjugated |
| 形式 | Liquid |
| 纯化方式 | Protein A purification |
| UNIPROT ID | P08729 |
| 储存缓冲液 | PBS with 0.02% sodium azide and 50% glycerol, pH 7.3. |
| 储存条件 | Store at -20°C. Stable for one year after shipment. Aliquoting is unnecessary for -20oC storage. |
背景介绍
Keratins are a large family of proteins that form the intermediate filament cytoskeleton of epithelial cells, which are classified into two major sequence types. Type I keratins are a group of acidic intermediate filament proteins, including K9-K23, and the hair keratins Ha1-Ha8. Type II keratins are the basic or neutral courterparts to the acidic type I keratins, including K1-K8, and the hair keratins, Hb1-Hb6. KRT7, also named as cytokeratin 7, is one member of type II basic cytokeratin. It is specifically expressed in the simple epithelia lining the cavities of the internal organs and in the gland ducts and blood vessels, and their neoplasms. KRT7 is marker of epithelial tissues, but not present in carcinomas of stratified squamous cell origin.This antibody is specifically against KRT7.
实验方案
| Product Specific Protocols | |
|---|---|
| IF protocol for Cytokeratin 7 antibody 66483-1-Ig | Download protocol |
| IHC protocol for Cytokeratin 7 antibody 66483-1-Ig | Download protocol |
| WB protocol for Cytokeratin 7 antibody 66483-1-Ig | Download protocol |
| Standard Protocols | |
|---|---|
| Click here to view our Standard Protocols |
发表文章
| Species | Application | Title |
|---|---|---|
Oxid Med Cell Longev Deletion of ACLY Disrupts Histone Acetylation and IL-10 Secretion in Trophoblasts, Which Inhibits M2 Polarization of Macrophages: A Possible Role in Recurrent Spontaneous Abortion. | ||
Front Oncol Significance of mouse xenograft tumor model using patient-derived cancer organoids for clinical drug development | ||
Sci Rep Long-term expansion of basal cells and the novel differentiation methods identify mechanisms for switching Claudin expression in normal epithelia | ||
Life Sci Cyclophilin A inhibits trophoblast migration and invasion in vitro and vivo through p38/ERK/JNK pathways and causes features of preeclampsia in mice. | ||
Placenta MiR-187 regulates the proliferation, migration and invasion of human trophoblast cells by repressing BCL6-mediated activation of PI3K/AKT signaling. | ||
Gene Comprehensive analysis of placental gene-expression profiles and identification of EGFR-mediated autophagy and ferroptosis suppression in intrahepatic cholestasis of pregnancy. |